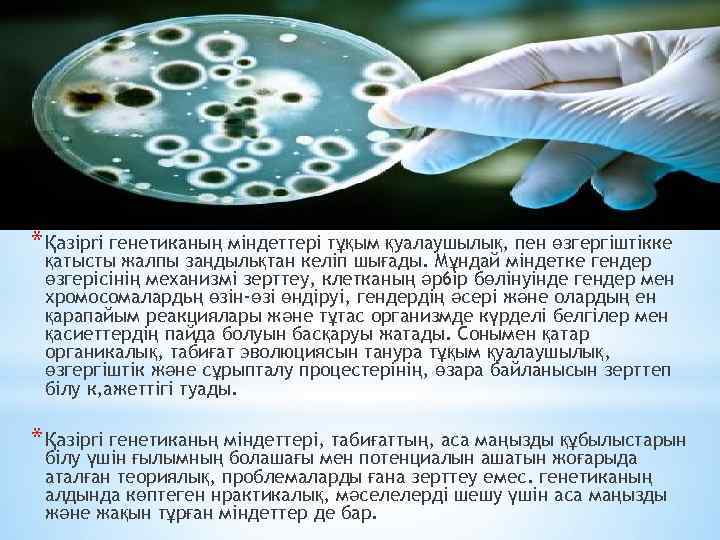
* Қaзipri генетиканың міндеттері тұқым қуалаушылық, пен өзгергіштікке қатысты жалпы заңдыльқтан келіп шығады. Мұндай

Каркын Кайсар 202.pptx
- Количество слайдов: 14

Семей Мемлекеттік Медицина Университеті Микробиология және молекулалық биология кафедрасы СӨЖ тақырыбы: Заманауи генетикалық әдістер. ТПР, ДНҚ зондтары. Заманауи вакциналарды жасап шығару қағидалары Орындаған: Қарқын Қайсар Тексерген: М. Т Семей 2014

* * Кіріспе * Негізгі бөлім * Генетика туралы түсінік * Заманауи генетикалық әдістер * нанотехнология жетістіктері * Вакцина * Заманауи вакцина жасап шығару Қағидалары * Қорытынды * Пайдаланылған әдебиеттер

*Генетика — бүкіл тірі ағзаларға тән тұқым қуалаушылық пен өзгергіштікті зерттейтін биология ғылымының бір саласы. Ағзалардың тұқым қуалаушылығы мен өзгергіштігі туралы ғылымды генетика деп атайды (грекше “genetіkos” — шығу тегіне тән). Бұл атауды 1906 жылы ағылшын биологы У. Бэтсон ұсынды.

*Қазақстанда тұңғыш рет М. А. Айтхожиннің басқаруымен молекулалық биология және ген инженериясы саласында көптеген зерттеулер жүргізіліп, ғылымға айтарлықтай жаңалықтар қосылды. Соңғы жылдары елімізде генетиканың аса маңызды салалары: молекулалық генетика, экологиялық генетика және радиациялық генетика бойынша ғылыми-зерттеу жұмыстары жүргізілуде
* Қaзipri генетиканың міндеттері тұқым қуалаушылық, пен өзгергіштікке қатысты жалпы заңдыльқтан келіп шығады. Мұндай міндетке гендер өзгерісінің механизмі зерттеу, клетканың әp 6 ip бөлінуінде гендер мен хромосомалардьң өзін-өзі өндіруі, гендердің әсері және олардың ен қарапайым реакциялары және тұтас организмде күрделі белгілер мен қасиеттердің пайда болуын басқаруы жатады. Сонымен қатар органикалық, табиғат эволюциясын танура тұқым қуалаушылық, өзгергіштік және сұрыпталу процестерінің, өзара байланысын зерттеп білу к, ажеттігі туады. * Қaзipri генетиканьң міндеттері, табиғаттың, аса маңызды құбылыстарын білу үшін ғылымның болашағы мен потенциалын ашатын жоғарыда аталған теориялық, проблемаларды ғана зерттеу емес. генетиканың алдында көптеген нрактикалық, мәселелерді шешу үшін аса маңызды және жақын тұрған міндеттер де бар.

Космостағы зерттеулерге байланысты радиацияльқ генетиканьң дамуы аса қажетті болып отыр. Космосқа ұшқанда адам космостық, сәулелердің әсеріне ұшырайды. Бұдан космостьқ генетика проблемаларыньң 6 ipi — осы сәулелер қаупіне генеткалық, баға беру проблемасы шығады. Антибиотиктердіц ашылуына байланысты генетика фармацевтік өнеркәсіпте ерекше роль атқарады. Миллиондаған өмірге араша болған антибиотиктерге (пенициллин, стрептомицин, биомицин) генетика жетістжтері арқасында ғана қол жетіп отыр. Бұл үшін антибиотиктер шығарушы продуценттердің қолдан алынған және ұрпағы өзгерген формалары пайдаланылды, олардьң өнімділігі табиғи формалардан жүздеген есе артьқ болып шықты.

* Біріншіден, осының көмегіне сүйене отырып, атомдарды өз қалауымызша тікелей орналастыру * * * жүзеге асырылады, яғни ерекше қасиеттерге ие болған материалдар жасалады. Екіншіден, көлемдері жекелеген молекулаларға немесе атомдарға тең белсенді элементтері бар электрондық схемалардың өндірісін ұйымдастыру көзделіп отыр. Үшіншіден, ғалымдар көлемі молекулаға тең механизмдер мен роботтар, яғни наномашина жасауды көздеуде. Бұл әрине, енді ғана қолға алына бастаған, тәжірибе жүзінде сынақтан өткен алғашқы қадамдар ғана. Бірақ ғылымы мен білімі дамыған бірқатар елдерде соның алғашқы үлгілері қолданысқа енгізіле бастады. Мәселен, Массачусетс технологиялық институтында қазір көлемі бақыр ақшадай өрмекші-роботтың алғашқы үлгісі жасалынды, ол бір минутта 10000 -ға дейін әртүрлі қозғалыстарға келтіріледі. Бірақ көлемі үлкен болғандықтан, оны нағыз наноробот деуге ертерек секілді. Ресей ғалымдары да америкалық әріптестерінен қалысар емес. Олар нанотехнологияны медицина саласына жұмыс істету жолында ғылыми-зерттеу жұмыстарын жүргізуде.

*ДНҚ зонд яғни бұл ДНҚ және РНҚ нуклеиодтармен бірін толықтырушы. Зонд бір цептік гибридтелген нуклеин қышқылдарының туындысы.
 — микроорганизмдерден (бактерия, вирус, т. б. Вакцина [1](лат. vacca — сиыр, vaccіnus — сиырдікі) — микроорганизмдерден (бактерия, вирус, т. б.](https://present5.com/presentation/197510353_329084734/image-9.jpg)
Вакцина [1](лат. vacca — сиыр, vaccіnus — сиырдікі) — микроорганизмдерден (бактерия, вирус, т. б. ) алынып, адам мен жануарлар организміне жұқпалы аурулардан алдын ала сақтану және олардың иммундық қасиетін арттыру үшін егілетін препараттар. Азиялық көшпелілер ежелгі дәуірден-ақ адам мен малға шешекті, ешкіге кебенекті, сиырға алаөкпені егу арқылы оларды қатерлі аурулардан сақтандырып отырған.

Тірі вакцина — микробтардың уыттылығын әлсіретіп, ауру тудырғыш қабілетін жою, иммунитет қалыптастыру үшін алынады. Алғаш рет француз микробиологы Л. Пастер тірі вакцинаны түйнемеге (1881) және құтыру ауруына (1885) қарсы қолданды. Ал 1926 жылы француз ғалымдары А. Кальмет пен К. Гереннің ашқан тірі туберкулез (БЦЖ) вакцинасы ғылымдағы үлкен жаңалық болды. Тірі вакциналар шешек, құтыру, оба, туляремия, т. б. ауруларға қарсы пайдаланылады

*Өлтірілген Вакцина — микроорганизмдерді физикалық (қыздыру арқылы) және химиялық жолмен (фенол, ацетон және спиртпен өңдеу) өлтіру әдістері арқылы алынады. Бұлардың қорғаныштық қабілеті тірі вакцинаға қарағанда төмендеу болғандықтан бірнеше рет егіледі.

*Химиялық вакцина — микроорганизмдерден бөлінетін активті антигендерден алынады. Бұл вакциналар паратиф, іш сүзегі, т. б. ауруларға қарсы пайдаланылады. Анатоксиндер — улы токсиндерді формалинмен өңдеу арқылы алынған усыз вакциналар. Бұларды алғаш рет (1923 — 1926) француз ғалымы Г. Рамон алды. Анатоксиндер дифтерия (күл), ботулизм, сіреспе, т. б. ауруларға қарсы қолданылады.

Ассоциацияланған Вакцина — 2 — 3 ауруға бірден қолданылатын вакциналар. Мысалы, сиырларды қараталақ пен қарасан (эмкар) ауруына қарсы бір вакцинамен егіп тастау өте тиімді. Вакциналарды организмге әр түрлі әдіспен енгізеді. Мысалы, шешек, туберкулез вакцинасын тері үстіне (тырнап), полиомиелитке қарсы ауыздан, гриптікін танау қуысынан құяды. Сүзек, тырысқақ, топалаң, құтыру вакцинасын тері астына, қызылша мен қарасан вакцинасын бұлшық етке егеді. Вакцина егілген организмде ауруға қарсы иммунитет 2 — 3 аптадан кейін қалыптасып, бірнеше жылдар бойы сақталады

Каркын Кайсар 202.pptx